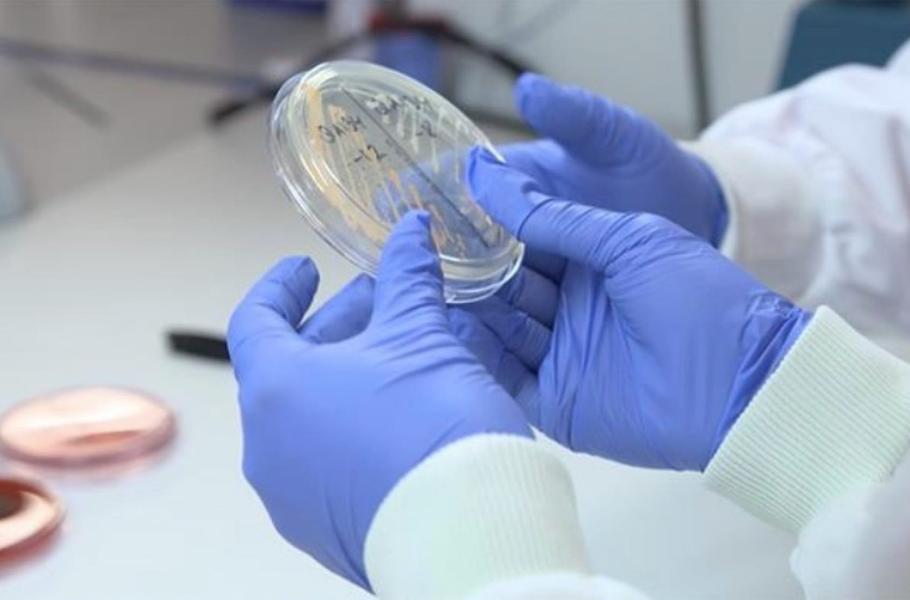

Nemocniční infekce jsou strašákem dnešní doby. Smutným paradoxem je, že právě používání antibiotik v nemocnicích přispělo k šíření rezistentních bakterií, které jsou za nemocniční infekce zodpovědné. Odborníci proto hledají cesty, jak s těmito infekcemi zatočit bez antibiotik.
Britští vědci vymysleli nové lékařské rukavice, které nepotřebují žádná antibiotika, a přesto zabíjejí bakterie dotykem. Ve spolupráci s výrobcem lékařských rukavic Hartalega Malaysia a výzkumnou společností Chemical Intelligence UK zabudovali do materiálu rukavic novou molekulu, která aktivně likviduje mikroby.
TIP: Světélkující „živé“ rukavice pomohou kriminalistům na místě činu
V laboratorních testech tyto rukavice pozabíjejí 99,9 procent mikroorganismů, které s nimi přijdou do kontaktu, za pouhých 5 minut. Rukavice by měly být levné, což by je mělo dostat do nemocnic po celém světě, včetně rozvojových a chudých oblastí.